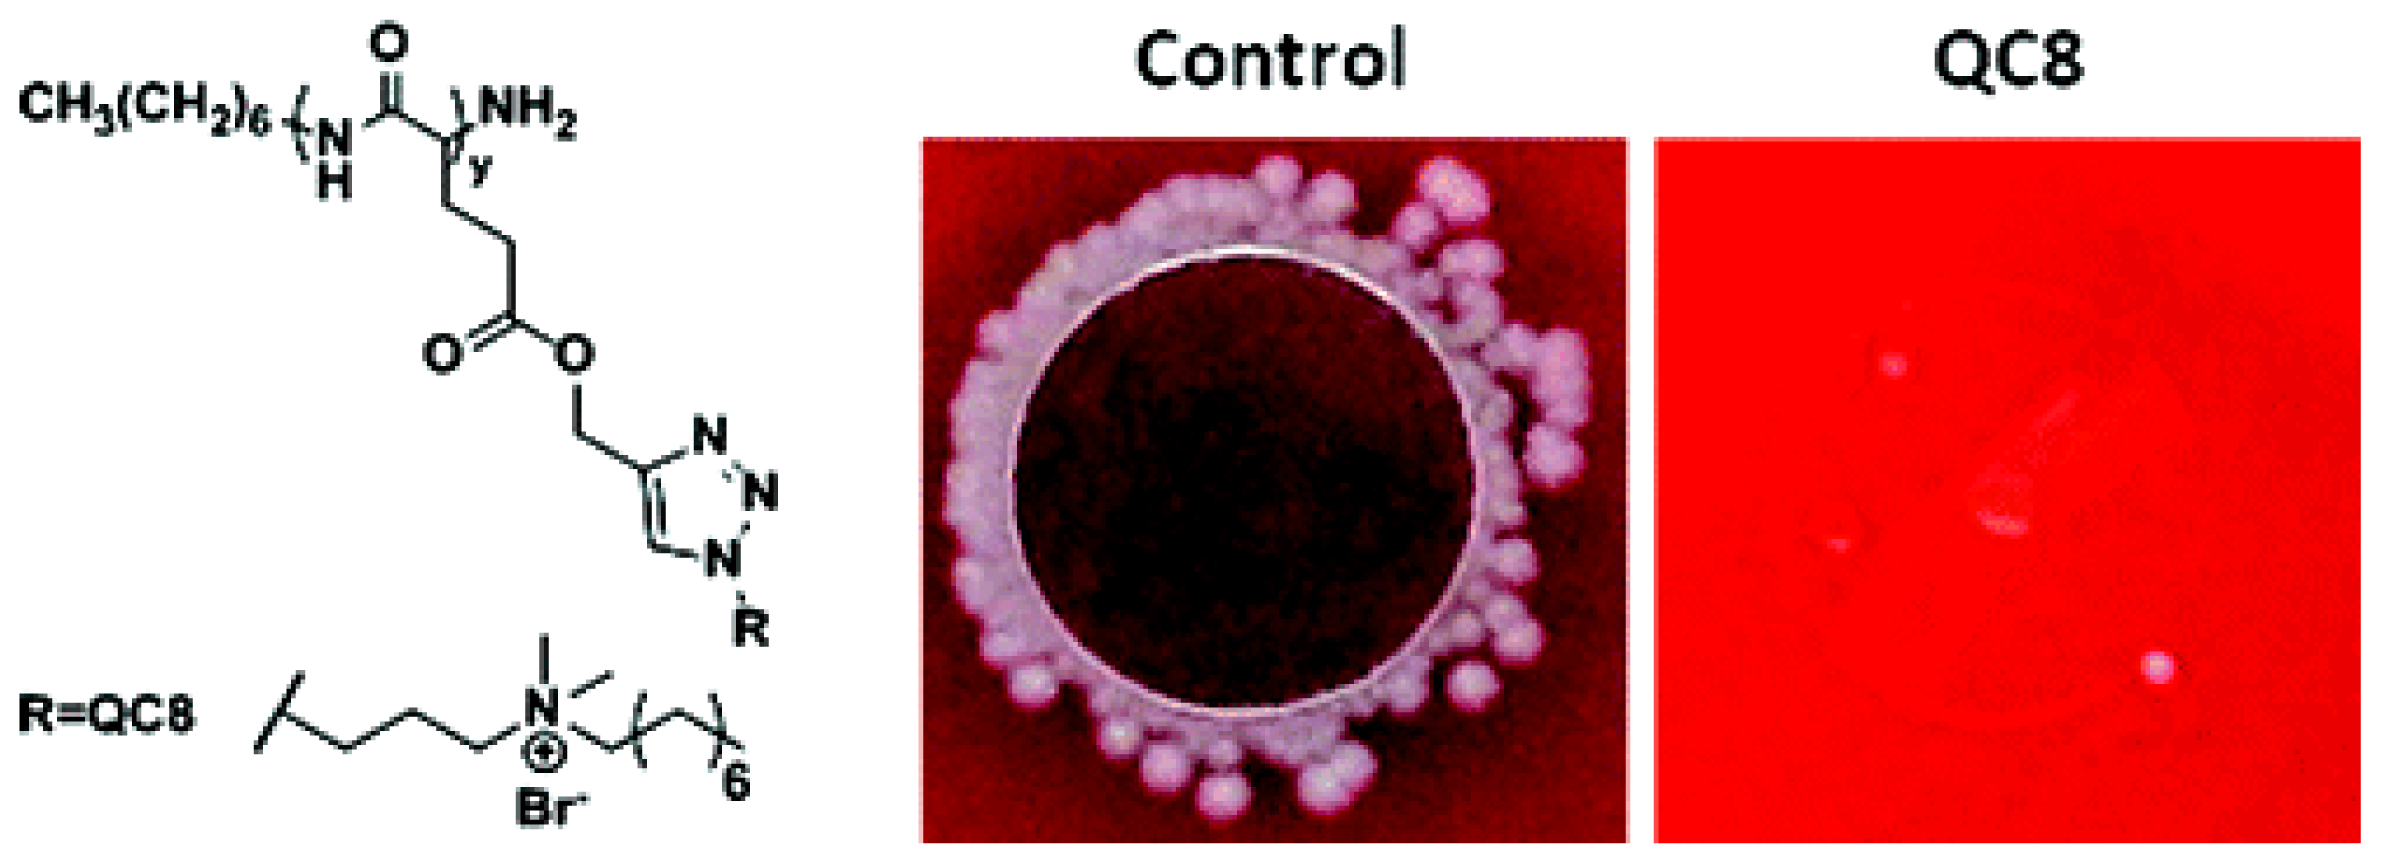
Ijms 14 09906f6 1024

Cationic Antimicrobial Polymers and Their Assemblies
Abstract
:1. Introduction
2. Cationic Antimicrobial Surfactants, Lipids and Polymers
3. The Antimicrobial Supramolecular Assemblies
4. Conclusions
Acknowledgments
Conflict of Interest
References
- McDonnell, G.; Russell, A.D. Antiseptics and disinfectants: Activity, action, and resistance. Clin. Microbiol. Rev 1999, 12, 147–179. [Google Scholar]
- Larson, E.L. Antiseptics. In APIC Infection Control & Applied Epidemiology: Principles & Practices; Olmstad, R.N., Ed.; Mosby-Year Book, Inc: St. Louis, MO, USA, 1996. [Google Scholar]
- Rutala, W.A.; Weber, D.J. Disinfection and sterilization in health care facilities: What clinicians need to know. Clin. Infect. Dis 2004, 39, 702–709. [Google Scholar]
- Block, S.S. Historical Review. In Disinfection, Sterilization, and Preservation, 5th ed; Block, S.S., Ed.; Lippincott Williams & Wilkins: Philadelphia, PA, USA, 2001; pp. 3–18. [Google Scholar]
- Frier, M. Derivatives of 4-Amino-quinaldinium and 8-Hydroxyquinolone. In Inhibition and Destruction of the Microbial Cell; Hugo, W.B., Ed.; Academic Press, Ltd: London, UK, 1971; pp. 107–120. [Google Scholar]
- Merianos, J.J. Quaternary Ammonium Antimicrobial Compounds. In Disinfection, Sterilization, and Preservation, 4th ed; Block, S.S., Ed.; Lea & Febiger: Philadelphia, PA, USA, 1991; pp. 225–255. [Google Scholar]
- Hugo, W.B.; Frier, M. Mode of action of antibacterial compound dequalinium acetate. Appl. Microbiol 1969, 17, 118–127. [Google Scholar]
- Hugo, W.B. Disinfection Mechanisms. In Principles and Practice of Disinfection, Preservation and Sterilization, 3rd ed; Russell, A.D., Hugo, W.B., Ayliffe, G.A.J., Eds.; Blackwell Scientific Publications: Oxford, UK, 1999; pp. 258–283. [Google Scholar]
- Salton, M.R.J. Lytic agents, cell permeability and monolayer penetrability. J. Gen. Physiol 1968, 52, 277S–252S. [Google Scholar]
- Denyer, S.P. Mechanisms of action of antibacterial biocides. Int. Biodeterior. Biodegradation 1995, 36, 227–245. [Google Scholar]
- Davies, A.; Field, B.S. Action of biguanides, phenols and detergents on Escherichia coli and its sphereoplasts. J. Appl. Bacteriol 1969, 32, 233–243. [Google Scholar]
- Kanazawa, A.; Ikeda, T.; Endo, T. A novel approach to mode of action of cationic biocides: Morphological effect on antibacterial activity. J. Appl. Bacteriol 1995, 78, 55–60. [Google Scholar]
- Russell, A.D.; Chopra, I. Understanding Antibacterial Action and Resistance, 2nd ed; Ellis Horwood: Chichester, UK, 1996. [Google Scholar]
- Cabral, J.P.S. Mode of antibacterial action of dodine (dodecylguanidine monoacetate) in Pseudomonas syringae. Can. J. Microbiol 1992, 38, 115–123. [Google Scholar]
- Codling, C.E.; Maillard, J.Y.; Russell, A.D. Aspects of the antimicrobial mechanisms of action of a polyquaternium and an amidoamine. J. Antimicrob. Chemother 2003, 51, 1153–1158. [Google Scholar]
- Campanhã, M.T.N.; Mamizuka, E.M.; Carmona-Ribeiro, A.M. Interactions between cationic liposomes and bacteria: The physical-chemistry of the bactericidal action. J. Lipid Res 1999, 40, 1495–1500. [Google Scholar]
- Martins, L.M.S.; Mamizuka, E.M.; Carmona-Ribeiro, A.M. Cationic vesicles as bactericides. Langmuir 1997, 13, 5583–5587. [Google Scholar]
- Kuegler, R.; Bouloussa, O.; Rondelez, F. Evidence of a charge-density threshold for optimum efficiency of biocidal cationic surfaces. Microbiology 2005, 151, 1341–1348. [Google Scholar]
- Endo, Y.; Tani, T.; Kodama, M. Antimicrobial activity of tertiary amine covalently bonded to a polystyrene fiber. Appl. Environ. Microbiol 1987, 53, 2050–2055. [Google Scholar]
- Fidai, S.; Farer, S.W.; Hancock, R.E. Interaction of cationic peptides with bacterial membranes. Methods Mol. Biol 1997, 78, 187–204. [Google Scholar]
- Friedrich, C.L.; Moyles, D.; Beverige, T.J.; Hancock, R.E. Antibacterial action of structurally diverse cationic peptides on gram-positive bacteria. Antimicrob. Agents Chemother 2000, 44, 2086–2092. [Google Scholar]
- Isquith, A.J.; Abbott, E.A.; Walters, P.A. Surface-bonded antimicrobial activity of an organosilicon quaternary ammonium chloride. Appl. Microbiol 1972, 24, 859–863. [Google Scholar]
- Tapias, G.N.; Sicchierolli, S.M.; Mamizuka, E.M.; Carmona-Ribeiro, A.M. Interactions between cationic vesicles and Escherichia coli. Langmuir 1994, 10, 3461–3465. [Google Scholar]
- Sicchierolli, S.M.; Mamizuka, E.M.; Carmona-Ribeiro, A.M. Bacteria flocculation and death by cationic vesicles. Langmuir 1995, 11, 2991–2995. [Google Scholar]
- Campanhã, M.T.N.; Mamizuka, E.M.; Carmona-Ribeiro, A.M. Interactions between cationic vesicles and Candida albicans. J. Phys. Chem. B 2001, 105, 8230–8236. [Google Scholar]
- Lincopan, N.; Mamizuka, E.M.; Carmona-Ribeiro, A.M. In vivo activity of a novel amphotericin B formulation with synthetic cationic bilayer fragments. J. Antimicrob. Chemother 2003, 52, 412–418. [Google Scholar]
- Lincopan, N.; Mamizuka, E.M.; Carmona-Ribeiro, A.M. Low nephrotoxicity of an effective amphotericin B formulation with cationic bilayer fragments. J. Antimicrob. Chemother 2005, 55, 727–734. [Google Scholar]
- Thome, J.; Holländer, A.; Jaeger, W.; Trick, I.; Oehr, C. Ultrathin antibacterial polyammonium coatings on polymer surfaces. Surf. Coat. Technol. 2003, 174–175, 584–587. [Google Scholar]
- Kanazawa, A.; Ikeda, T.; Endo, T. Novel polycationic biocides: Synthesis and antibacterial activity of polymeric phosphonium salts. J. Polym. Sci. A 1993, 31, 335–343. [Google Scholar]
- Popa, A.; Davidescu, C.M.; Trif, R.; Ilia, G.H.; Iliescu, S.; Dehelean, G.H. Study of quaternary ‘onium’ salts grafted on polymers: Antibacterial activity of quaternary phosphonium salts grafted on ‘gel-type’ styene-divinylbenzene copolymers. React. Funct. Polym 2003, 55, 151–158. [Google Scholar]
- Tiller, J.C.; Liao, C.; Lewis, K.; Klibanov, A.M. Designing surfaces that kill bacteria on contact. Proc. Natl. Acad. Sci. USA 2001, 98, 5981–5985. [Google Scholar]
- Vieira, D.B.; Lincopan, N.; Mamizuka, E.M.; Petri, D.F.S.; Carmona-Ribeiro, A.M. Competitive adsorption of cationic bilaers and chitosan on latex: Optimal biocidal action. Langmuir 2003, 19, 924–932. [Google Scholar]
- Cen, L.; Neoh, K.G.; Kang, E.T. Surface functionalization technique for conferring antibacterial properties to polymeric and cellulosic surfaces. Langmuir 2003, 19, 10295–10303. [Google Scholar]
- Chen, C.Z.; Cooper, S.L. Recent advances in antimicrobial dendrimers. Adv. Mater 2000, 12, 843–846. [Google Scholar]
- Chen, C.Z.; Cooper, S.L. Interactions between dendrimer biocides and bacterial membranes. Biomaterials 2002, 23, 3359–3368. [Google Scholar]
- Carmona-Ribeiro, A.M.; Chaimovich, H. Preparation and characterization of large dioctadecyl dimethylammonium chloride liposomes and comparison with small sonicated vesicles. Biochim. Biophys. Acta 1983, 733, 172–179. [Google Scholar]
- Carmona-Ribeiro, A.M.; Yoshida, L.S.; Chaimovich, H. Salt effects on the stability of dioctadecyldimethylammonium chloride and sodium dihexadecyl phosphate vesicles. J. Phys. Chem 1985, 89, 2928–2933. [Google Scholar]
- Carmona-Ribeiro, A.M.; Chaimovich, H. Salt-induced aggregation and fusion of dioctadecyl dimethylammonium chloride and sodium dihexadecylphosphate vesicles. Biophys. J 1986, 50, 621–628. [Google Scholar]
- Carmona-Ribeiro, A.M. Synthetic amphiphile vesicles. Chem. Soc. Rev 1992, 21, 209–214. [Google Scholar]
- Vieira, D.B.; Carmona-Ribeiro, A.M. Synthetic bilayer fragments for solubilization of amphotericin B. J. Colloid Interface Sci 2001, 244, 427–431. [Google Scholar]
- Carmona-Ribeiro, A.M. Lipid-Based Biomimetics in Drug and Vaccine Delivery. In Biomimetics Learning from Nature; Mukherjee, A., Ed.; InTech: Vulkovar, Croatia, 2010; pp. 507–534. [Google Scholar]
- Carmona-Ribeiro, A.M.; Barbassa, L.; Melo, L.D. Antimicrobial Biomimetics. In Biomimetic Based Applications; Cavrak, M., Ed.; InTech: Rijeka, Croatia, 2011; pp. 227–284. [Google Scholar]
- Ahlstrom, B.; Chelminska-Bertilsson, M.; Thompson, R.A.; Edebo, L. Submicellar complexes may initiate the fungicidal effects of cationic amphiphilic compounds on Candida albicans. Antimicrob. Agents Chemother 1997, 41, 544–550. [Google Scholar]
- Vieira, D.B.; Carmona-Ribeiro, A.M. Cationic lipids and surfactants as antifungal agents: Mode of action. J. Antimicrob. Chemother 2006, 58, 760–767. [Google Scholar]
- Melo, L.D.; Mamizuka, E.M.; Carmona-Ribeiro, A.M. Antimicrobial particles from cationic lipid and polyelectrolytes. Langmuir 2010, 26, 12300–12306. [Google Scholar]
- Carmona-Ribeiro, A.M.; Midmore, B.R. Synthetic bilayer adsorption onto polystyrene microspheres. Langmuir 1992, 8, 801–806. [Google Scholar]
- Rosa, H.; Petri, D.F.S.; Carmona-Ribeiro, A.M. Interactions between bacteriophage DNA and cationic biomimetic particles. J. Phys. Chem. B 2008, 112, 16422–16430. [Google Scholar]
- Lambert, P.A.; Hammond, S.M. Potassium fluxes, first indications of membrane damage in micro-organisms. Biochem. Biophys. Res. Commun 1973, 54, 796–799. [Google Scholar]
- Menschutkin, N. Beiträgen zur kenntnis der affinitätskoeffizienten der alkylhaloide und der organischen amine. Z. Phys. Chem 1890, 5, 589–601. [Google Scholar]
- Jacobs, W.A.; Heidelberger, M. The quaternary salts of hexamethylenetetramine. I. Substituted benzyl halides and the hexamethylenetetraminium salts derived therefrom. J. Biol. Chem 1915, 20, 659–683. [Google Scholar]
- Jacobs, W.A.; Heidelberger, M. The quaternary salts of hexamethylenetetramine. II. Monohalogenacetylbenzylamines and their hexamethylenetetraminium salts. J. Biol. Chem 1915, 20, 685–694. [Google Scholar]
- Jacobs, A.A.; Heidelberger, M. The quaternary salts of hexamethylenetetramine. III. monohalogenacylated aromatic amines and their hexamethylenetetraminium salts. J. Biol. Chem 1915, 21, 103–143. [Google Scholar]
- Jacobs, W.A. Tile bactericidal properties of the quaternary salts of hexamethylenetetramine. I. The problem of the chemotherapy of experimental bacterial infections. J. Exp. Med 1916, 23, 563–568. [Google Scholar]
- Domagk, G. A new class of disinfectant. Dtsch. Med. Wochenschr 1935, 61, 829–832. [Google Scholar]
- Denmark, S.E.; Gould, N.D.; Wolf, L.M. A systematic investigation of quaternary ammonium ions as asymmetric phase-transfer catalysts. Application of quantitative structure activity/selectivity relationships. J. Org. Chem 2011, 76, 4337–4357. [Google Scholar]
- Butenschön, H. Book Review: Organic syntheses based on name reactions and unnamed reaction. By Hassner, A., Stumer, C. Angew. Chem. Int. Ed. Engl 1995, 34, 935–936. [Google Scholar]
- Butcher, J.A.; Preston, A.F.; Drysdale, J. Initial screening trials of some quaternary ammonium compounds and amine salts as wood preservatives. Forest Product J 1977, 27, 19–22. [Google Scholar]
- Butcher, J.A.; Drysdale, J. Relative tolerance of 7 wood-destroying basidiomycetes to quaternary ammonium-compounds and copper-chrome-arsenate preservative. Mater. Organismen 1977, 12, 271–277. [Google Scholar]
- Welton, T. Room-temperature ionic liquids. Solvents for synthesis and catalysis. Chem. Rev 1999, 99, 2071–2083. [Google Scholar]
- Wasserscheid, P.; Keim, W. Ionic liquids—New “solutions” for transition metal catalysis. Angew. Chem. Int. Ed. Engl 2000, 39, 3772–3789. [Google Scholar]
- Sheldon, R. Catalytic reactions in ionic liquids. Chem. Commun 2001, 23, 2399–2407. [Google Scholar]
- Olivier-Bourbigou, H.; Magna, L. Ionic liquids: Perspectives for organic and catalytic reactions. J. Mol. Catal. A Chem. 2002, 182–183, 419–437. [Google Scholar]
- Dupont, J.; de Souza, R.F.; Suarez, P.A.Z. Ionic liquid (molten salt) phase organometallic catalysis. Chem. Rev 2002, 102, 3667–3691. [Google Scholar]
- Earle, M.J. Ionic Liquids: Solvents for the Twenty-First Century. In Ionic Liquids: Industrial Applications for Green Chemistry; Rogers, R.D., Seddon, K.R., Eds.; ACS Symposium Series: Washington D.C., WA, USA, 2002; Volume 818, pp. 90–105. [Google Scholar]
- Davis, H., Jr.; Gordon, C.M.; Hilgers, C.; Wasserscheid, P. Synthesis and Purification of Ionic Liquids. In Ionic Liquids in Synthesis; Wasserscheid, P., Welton, T., Eds.; Wiley-VCH Verlag GmbH & Co. KgaA: Weinheim, Germany, 2002; pp. 7–40. [Google Scholar]
- Sidhu, M.S.; Sorum, H.; Holck, A. Resistance to quaternary ammonium compounds in food-related bacteria. Microb. Drug Resist 2002, 8, 393–399. [Google Scholar]
- Carmona-Ribeiro, A.M.; Vieira, D.B.; Lincopan, N. Cationic lipids and surfactants as anti-infective agents. Anti-Infect. Agents Med. Chem 2006, 5, 33–54. [Google Scholar]
- Nishihara, T.; Okamoto, T.; Nishiyama, N. Biodegradation of didecyldimethylammonium chloride by Pseudomonas fluorescens TN4 isolated from activated sludge. J. Appl. Microbiol 2000, 88, 641–647. [Google Scholar]
- Arnt, L.; Tew, G.N. New poly(phenyleneethynylene)s with cationic, facially amphiphilic structures. J. Am. Chem. Soc 2002, 124, 7664–7665. [Google Scholar]
- Diaz, T.; Fischer, A.; Jonquières, A.; Brembilla, A.; Lochon, P. Controlled polymerization of functional monomers and synthesis of block copolymers using beta-phosphonylated nitroxide. Macromolecules 2003, 36, 2235–2241. [Google Scholar]
- Jaeger, W.; Wendler, U.; Lieske, A.; Bohrisch, J. Novel modified polymers with permanent cationic groups. Langmuir 1999, 15, 4026–4032. [Google Scholar]
- Oster, C.G.; Wittmar, M.; Unger, F.; Barbu-Tudoran, L.; Schaper, A.K.; Kissel, T. Design of amine-modified graft polyesters for effective gene delivery using DNA-loaded nanoparticles. Pharm. Res 2004, 21, 927–931. [Google Scholar]
- Tadros, T. Polymeric surfactants in disperse systems. Adv. Colloid Interface Sci. 2009, 147–148, 281–299. [Google Scholar]
- Summers, M.; Eastoe, J. Concentrated polymerized cationic surfactant phases. Langmuir 2003, 19, 6357–6362. [Google Scholar]
- Chung, M.-H.; Park, J.-H.; Chun, B.C.; Chung, Y.-C. Polymerizable ion-pair amphiphile that has a polymerizable group at cationic ammonium chain. Colloids Surf. B Biointerfaces 2004, 39, 165–170. [Google Scholar]
- Liu, S.Y.; González, Y.I.; Kaler, E.W. Structural fixation of spontaneous vesicles in aqueous mixtures of polymerizable anionic and cationic surfactants. Langmuir 2003, 19, 10732–10738. [Google Scholar]
- Holmberg, K. Novel Surfactants. Preparation, Applications, and Biodegradability, 2nd ed; Surfactant Science Series: Berkshire, UK, 2003. [Google Scholar]
- Gerber, M.J.; Kline, S.R.; Walker, L.M. Characterization of rodlike aggregates generated from a cationic surfactant and a polymerizable counterion. Langmuir 2004, 20, 8510–8516. [Google Scholar]
- Deen, G.R.; Gan, L.H.; Gan, Y.Y. A new cationic surfactant N,N′-dimethyl-N-acryloyloxyundecyl piperazinium bromide and its pH-sensitive gels by microemulsion polymerization. Polymer 2004, 45, 5483–5490. [Google Scholar]
- Zelikin, A.N.; Putnam, D.; Shastri, P.; Langer, R.; Izumrudov, V.A. Aliphatic ionenes as gene delivery agents: Elucidation of structure-funtion relationship through modification of charge density and polymer length. Bioconjug. Chem 2002, 13, 548–553. [Google Scholar]
- Izumrudov, V.A.; Zhiryakova, M.V.; Kudaibergenov, S.E. Controllable stability of DNA-containing polyelectrolyte complexes in water-salt solutions. Biopolymers 1999, 52, 94–108. [Google Scholar]
- Aubin, R.A.; Weinfeld, M.; Mirzayans, R.; Paterson, M.C. Polybrene/DMSO-assisted gene transfer generating stable transfectants with nanogram amounts of DNA. Mol. Biotechnol 1994, 1, 29–48. [Google Scholar]
- Rembaum, A.; Baumgartner, W.; Eisenberg, A. Aliphatic ionenes. J. Polym. Sci. B 1968, 6, 159–171. [Google Scholar]
- Littmann, E.R.; Marvel, C.S. Cyclic quaternary ammonium salt from halogenated aliphatic tertiary amines. J. Am. Chem. Soc 1930, 52, 287–294. [Google Scholar]
- Zelikin, A.N.; Akritskaya, N.I.; Izumrudov, V.A. Modified aliphatic ionenes. Influence of charge density and length of the chains on complex formation with poly (methacrylic acid). Macromol. Chem. Phys 2001, 202, 3018–3026. [Google Scholar]
- Ikeda, T.; Yamaguchi, H.; Tazuke, S. Phase-separation in phospholipid bilayers induced by biologically-active polycations. Biochim. Biophys. Acta 1990, 1026, 105–112. [Google Scholar]
- Rembaum, A.; Senyei, A.E.; Rajaraman, R. Interaction of living cells with polyionenes and polyionene-coated surfaces. J. Biomed. Mater. Res 1977, 11, 101–110. [Google Scholar]
- Kimura, E.T.; Young, P.R.; Barlow, G.H. Study with low and high molecular weights of hexadimethrine bromide—An antiheparin agent. Exp. Biol. Med 1962, 111, 37–41. [Google Scholar]
- Putnam, D.; Gentry, C.A.; Pack, D.W.; Langer, R. Polymer-based gene delivery with low cytotoxicity by a unique balance of side chain termini. Proc. Natl. Acad. Sci. USA 2001, 98, 1200–1205. [Google Scholar]
- Wolfert, M.A.; Dash, P.R.; Nazarova, O.; Oupicky, D.; Seymour, L.W.; Smart, S.; Strhalm, J.; Ulbrich, K. Polyelectrolyte vectors for gene delivery: Influence of cationic polymer on biophysical properties of complexes formed with DNA. Bioconjug. Chem 1999, 10, 993–1004. [Google Scholar]
- Ilker, M.F.; Schule, H.; Coughlin, E.B. Modular norbornene derivatives for the preparation of well-defined amphiphilic polymers: Study of the lipid membrane disruptions activities. Macromolecules 2004, 37, 694–700. [Google Scholar]
- Ilker, M.F.; Nuesslein, K.; Tew, G.N.; Coughlin, E.B. Tuning the hemolytic and antibacterial activities of amphiphilic polynorbornene derivatives. J. Am. Chem. Soc 2004, 126, 15870–15875. [Google Scholar]
- Kusnetsov, J.M.; Tulkki, A.I.; Ahonen, H.E.; Martikainen, P.J. Efficacy of three prevention strategies against legionella in cooling water systems. J. Appl. Microbiol 1997, 82, 763–768. [Google Scholar]
- Messick, C.R.; Pendland, S.L.; Moshirfar, M.; Fiscella, R.G.; Losnedahl, K.J.; Schriever, C.A.; Schreckenberger, P.C. In-vitro activity of polyhexamethylene biguanide (PHMB) against fungal isolates associated with infective keratitis. J. Antimicrob. Chemother 1999, 44, 297–298. [Google Scholar]
- Donoso, R.; Mura, J.J.; Lopez, M. Acanthamoeba keratitis treated with propamidine and polyhexamethyl biguanide. Rev. Med. Chile 2002, 130, 396–401. [Google Scholar]
- Gray, T.B.; Gross, K.A.; Cursons, R.T.M.; Shewan, J.F. Acanthamoeba-keratitis—A sobering case and a promising new treatment. Aust. NZJ. Ophthalmol 1994, 22, 73–76. [Google Scholar]
- Narasimhan, S.; Madhavan, H.N.; Therese, L.K. Development and application of an in vitro susceptibility test for Acanthamoeba species isolated from keratitis to polyhexamethylene biguanide and chlorhexidine. Cornea 2002, 21, 203–205. [Google Scholar]
- Hiti, K.; Walochnik, J.; Haller-Schober, E.M.; Faschinger, C.; Aspock, H. Viability of Acanthamoeba after exposure to a multipurpose disinfecting contact lens solution and two hydrogen peroxide systems. Br. J. Ophthalmol 2002, 86, 144–146. [Google Scholar]
- Rosin, M.; Welk, A.; Bernhardt, O.; Ruhnau, M.; Pitten, F.A.; Kocher, T.; Kramer, A. Effect of a polyhexamethylene biguanide mouthrinse on bacterial counts and plaque. J. Clin. Periodontol 2001, 28, 1121–1126. [Google Scholar]
- Rosin, M.; Welk, A.; Kocher, T.; Majic-Todt, A.; Kramer, A.; Pitten, F.A. The effect of a polyhexamethylene biguanide mouthrinse compared to an essential oil rinse and a chlorhexidine rinse on bacterial counts and 4-day plaque regrowth. J. Clin. Periodontol 2002, 29, 392–399. [Google Scholar]
- Payne, J.D.; Kudner, D.W. A durable antiodor finish for cotton textiles. Text. Chem. Color 1996, 28, 28–30. [Google Scholar]
- Davis, S.; Mertz, P.M.; Cazzaniga, A.; Serralta, V.; Orr, R.; Eaglstein, W. The use of new antimicrobial gauze dressings: Effects on the rate of epithelization of partial-thickness wounds. Wounds 2002, 14, 252–256. [Google Scholar]
- Cox, N.A.; Bailey, J.S.; Berrang, M.E. Bactericidal treatment of hatching eggs I. Chemical immersion treatments and Salmonella. J. Appl. Poult. Res 1998, 7, 347–350. [Google Scholar]
- Cox, N.A.; Berrang, M.E.; Buhr, R.J.; Bailey, J.S. Bactericidal treatment of hatching eggs II. Use of chemical disinfectants with vaccum to reduce Salmonella. J. Appl. Poult. Res 1999, 8, 321–326. [Google Scholar]
- Allen, M.J.; Morby, A.P.; White, G.F. Cooperativity in the binding of the cationic biocide polyhexamethylene biguanide to nucleic acids. Biochem. Biophys. Res. Commun 2004, 318, 397–404. [Google Scholar]
- Zhou, Z.; Wei, D.; Guan, Y.; Zheng, A.; Zhong, J.-J. Extensive in vitro activity of guanidine hydrochloride polymer analogs against antibiotics-resistant clinically isolated strains. Mater. Sci. Eng. C 2011, 31, 1836–1843. [Google Scholar]
- Tashiro, T. Antibacterial and bacterium adsorbing macromolecules. Macromol. Mater. Eng 2001, 286, 63–87. [Google Scholar]
- Kawabata, N.; Nishiguchi, M. Antibacterial activity of soluble pyridinium-type polymers. Appl. Environ. Microbiol 1988, 54, 2532–2535. [Google Scholar]
- Carmona-Ribeiro, A.M. Bilayer-forming synthetic lipids: Drugs or carriers? Curr. Med. Chem 2003, 10, 2425–2446. [Google Scholar]
- Carmona-Ribeiro, A.M.; Ortis, F.; Schumacher, R.I.; Armelin, M.C.S. Interactions between cationic vesicles and cultures mammalian cells. Langmuir 1997, 13, 2215–2218. [Google Scholar]
- Eliyahu, H.; Barenholz, Y.; Domb, A.J. Polymers for DNA delivery. Molecules 2005, 10, 34–64. [Google Scholar]
- Tros de Ilarduya, C.; Sun, Y.; Düzgüneş, N. Gene delivery by lipoplexes and polyplexes. Eur. J. Pharm. Sci 2010, 40, 159–170. [Google Scholar]
- Niculescu-Duvaz, D.; Heyes, J.; Springer, C.J. Structure-activity relationship in cationic lipid mediated gene transfection. Curr. Med. Chem 2003, 10, 1233–1261. [Google Scholar]
- Pedroso de Lima, M.C.; Neves, S.; Filipe, A.; Duezgunes, N.; Simoes, S. Cationic liposomes for gene delivery: From biophysics to biological applications. Curr. Med. Chem 2003, 10, 1221–1231. [Google Scholar]
- Miller, A.D. The problem with cationic liposome/micelle-based non-viral vector systems for gene therapy. Curr. Med. Chem 2003, 10, 1195–1211. [Google Scholar]
- Safinya, C.R.; Lin, A.J.; Slack, N.L.; Koltover, I. Structure and Structure-Activity Correlations of Cationic Lipid/DNA Complexes: Supramolecular Assembly and Gene Delivery. In Pharmaceutical Perspectives of Nucleic Acid-Based Therapeutics; Mahato, R.I., Kim, S.W., Eds.; Taylor & Francis: London, UK, 2002; pp. 190–209. [Google Scholar]
- Belmont, P.; Aissaoui, A.; Hauchecorne, M.; Oudrhiri, N.; Petit, L.; Vigneron, J.-P.; Lehn, J.-M.; Lehn, P. Aminoglycoside-derived cationic lipids as efficient vectors for gene transfection in vitro and in vivo. J. Gene Med 2002, 4, 517–526. [Google Scholar]
- Simberg, D.; Weisman, S.; Talmon, Y.; Barenholz, Y. DOTAP (and other cationic lipids): Chemistry, biophysics and transfection. Crit. Rev. Ther. Drug Carrier Syst 2004, 21, 257–317. [Google Scholar]
- Aissaoui, A.; Martin, B.; Kan, E.; Oudrhiri, N.; Hauchecorne, M.; Vigneron, J.P.; Lehn, J.M.; Lehn, P. Novel cationic lipids incorporating an acid-sensitive acylhydrazone linker: Synthesis and transfection properties. J. Med. Chem 2004, 47, 5210–5223. [Google Scholar]
- Mahidhar, Y.V.; Rajesh, M.; Chaudhuri, A. Spacer-arm modulated gene delivery efficacy of novel cationic glycolipids: Design, synthesis and in vitro transfection biology. J. Med. Chem 2004, 47, 3938–3948. [Google Scholar]
- Ilies, M.A.; Seitz, W.A.; Ghiviriga, I.; Johnson, B.H.; Miller, A.; Thompson, E.B.; Balaban, A.T. Pyridinium cationic lipids in gene delivery: A strucuture-activity correlation study. J. Med. Chem 2004, 47, 3744–3754. [Google Scholar]
- Byk, G.; Dubertret, C.; Escriou, V.; Frederic, M.; Jaslin, G.; Rangara, R.; Pitard, B.; Crouzet, J.; Wils, P.; Schwartz, B.; et al. Synthesis, activity and structure-activity relationship studies of novel cationic lipids for DNA transfer. J. Med. Chem 1998, 41, 229–235. [Google Scholar]
- Smisterova, J.; Wagenaar, A.; Stuart, M.C.A.; Polushkin, E.; ten Brinke, G.; Hulst, R.; Engberts, J.B.F.N.; Hoekstra, D. Molecular shape of the cationic lipid controls the structure of cationic lipid/dioleylphosphatidylethanolamine-DNA complexes and the efficiency of gene delivery. J. Biol. Chem 2001, 276, 47615–47622. [Google Scholar]
- van der Woude, I.; Wagenaar, A.; Meekel, A.A.P.; ter Beest, M.B.A.; Ruiters, M.H.J.; Engberts, J.B.F.N.; Hoekstra, D. Novel pyridinium surfactants for efficient, nontoxic in vitro gene delivery. Proc. Natl. Acad. Sci. USA 1997, 94, 1160–1165. [Google Scholar]
- Karmali, P.P.; Kumar, V.V.; Chaudhuri, A. Design, synthesis and in vitro gene delivery efficacies of novel mono- and trilysinated cationic lipids: A structure-activity investigation. J. Med. Chem 2004, 47, 2123–2132. [Google Scholar]
- Floch, V.; Loisel, S.; Guenin, E.; Hervé, A.C.; Clement, J.C.; Yaouanc, J.J.; des Abbayes, H.; Férec, C. Cation substitution in cationic phosphonolipids: A new concept to improve transfection activity and decrease cellular toxicity. J. Med. Chem 2000, 43, 4617–4628. [Google Scholar]
- Jacopin, C.; Ho, H.; Scherman, D.; Herscovici, J. Synthesis and transfecting properties of a glycosylated polycationic DNA vector. Bioorg. Med. Chem. Lett 2001, 11, 419–422. [Google Scholar]
- Vigneron, J.P.; Oudrhiri, N.; Fauquet, M.; Vergely, L.; Bradley, J.C.; Basseville, M.; Lehn, P.; Lehn, J.M. Guanidinium-cholesterol cationic lipids: Efficient vectors for the transfection of eukaryotic cells. Proc. Natl. Acad. Sci. USA 1996, 93, 9682–9686. [Google Scholar]
- Patel, M.; Vivien, E.; Hauchecorne, M.; Oudrhiri, N.; Ramasawmy, R.; Vigneron, J.P.; Lehn, P.; Lehn, J.M. Efficient gene transfection by bisguanylated diacetylene lipid formulations. Biochem. Biophys. Res. Commun 2001, 281, 536–543. [Google Scholar]
- Marshall, J.; Nietupski, J.B.; Lee, E.R.; Siegel, C.S.; Rafter, P.W.; Rudginsky, S.A.; Chang, C.D.; Eastman, S.J.; Harris, D.J.; Scheule, R.K.; et al. Cationic lipid structure and formulation considerations for optimal gene transfection of the lung. J. Drug Target 2000, 7, 453–469. [Google Scholar]
- Layman, J.M.; Ramirez, S.M.; Green, M.D.; Long, T.E. Influence of polycation molecular weight on poly (2-dimethylaminoethyl methacrylate)-mediated DNA delivery in vitro. Biomacromolecules 2009, 10, 1244–1252. [Google Scholar]
- Matyjaszewski, K.; Davis, T.P. Handbook of Radical Polymerization; John Wiley & Sons: New York, NY, USA, 2002. [Google Scholar]
- Venkataraman, S.; Zhang, Y.; Liu, L.; Yang, Y.-Y. Design, syntheses and evaluation of hemocompatible pegylated-antimicrobial polymers with well-controlled molecular structures. Biomaterials 2010, 31, 1751–1756. [Google Scholar]
- Ji, W.; Panus, D.; Palumbo, R.N.; Tang, R.; Wang, C. Poly (2-aminoethyl methacrylate) with well-defined chain length for DNA vaccine delivery to dendritic cells. Biomacromolecules 2011, 12, 4373–4385. [Google Scholar]
- Kuroda, K.; DeGrado, W.F. Amphiphilic polymethacrylate derivatives as antimicrobial agents. J. Am. Chem. Soc 2005, 127, 4128–4129. [Google Scholar]
- Feder, R.; Dagan, A.; Mor, A. Structure-activity relationship study of antimicrobial dermaseptin S4 showing the consequences of peptide oligomerization on selective cytotoxicity. J. Biol. Chem 2000, 275, 4230–4238. [Google Scholar]
- Palermo, E.F.; Kuroda, K. Structural determinants of antimicrobial activity in polymers which mimic host defense peptides. Appl. Microbiol. Biotechnol 2010, 87, 1605–1615. [Google Scholar]
- Hamuro, Y.; Schneider, J.P.; DeGrado, W.F. De novo design of antibacterial beta-peptides. J. Am. Chem. Soc 1999, 121, 12200–12201. [Google Scholar]
- Patch, J.A.; Barron, A.E. Helical peptoid mimics of magainin-2 amide. J. Am. Chem. Soc 2003, 125, 12092–12093. [Google Scholar]
- Sellenet, P.H.; Allison, B.; Applegate, B.M.; Youngblood, J.P. Synergistic activity of hydrophilic modification in antibiotic polymers. Biomacromolecules 2007, 8, 19–23. [Google Scholar]
- Kuroda, K.; Caputo, G.A.; DeGrado, W.F. The role of hydrophobicity in the antimicrobial and hemolytic activities of polymethacrylate derivatives. Chemistry 2009, 15, 1123–1133. [Google Scholar]
- Mowery, B.P.; Lee, S.E.; Kissounko, D.A.; Epand, R.F.; Epand, R.M.; Weisblum, B.; Stahl, S.S.; Gellman, S.H. Mimicry of antimicrobial host-defense peptides by random copolymers. J. Am. Chem. Soc 2007, 129, 15474–15476. [Google Scholar]
- Palermo, E.F.; Lee, D.-K.; Ramamoorthy, A.; Kuroda, K. Role of cationic group structure in membrane binding and disruption by amphiphilic copolymers. J. Phys. Chem. B 2011, 115, 366–375. [Google Scholar]
- Azzam, T.; Domb, A.J. Current developments in gene transfection agents. Curr. Drug Deliv 2004, 1, 165–193. [Google Scholar]
- Khalil, H.; Chen, T.; Riffon, R.; Wang, R.; Wang, Z. Synergy between polyethylenimine and different families of antibiotics against a resistant clinical isolate of Pseudomonas aeruginosa. Antimicrob. Agents Chemother 2008, 52, 1635–1641. [Google Scholar]
- Fuchs, B.B.; Tegos, G.P.; Hamblin, M.R.; Mylonakis, E. Susceptibility of Cryptococcus neoformans to photodynamic inactivation is associated with cell wall integrity. Antimicrob. Agents Chemother 2007, 51, 2929–2936. [Google Scholar]
- Tegos, G.P.; Anbe, M.; Yang, C.; Demidova, T.N.; Satti, M.; Mroz, P.; Janjua, S.; Gad, F.; Hamblin, M.R. Protease-stable polycationic photosensitizer conjugates between polyethyleneimine and chlorin(e6) for broad-spectrum antimicrobial photoinactivation. Antimicrob. Agents Chemother 2006, 50, 1402–1410. [Google Scholar]
- Milovic, N.M.; Wang, J.; Lewis, K.; Klibanov, A.M. Immobilized N-alkylated polyethylenimine avidly kills bacteria by rupturing cell membranes with no resistance developed. Biotechnol. Bioeng 2005, 90, 715–722. [Google Scholar]
- Spoden, G.A.; Besold, K.; Krauter, S.; Plachter, B.; Hanik, N.; Kilbinger, A.F.; Lambert, C.; Florin, L. Polyethylenimine is a strong inhibitor of human papillomavirus and cytomegalovirus infection. Antimicrob. Agents Chemother 2012, 56, 75–82. [Google Scholar]
- Soukos, N.S.; Ximenez-Fyvie, L.A.; Hamblin, M.R.; Socransky, S.S.; Hasan, T. Targeted antimicrobial photochemotherapy. Antimicrob. Agents Chemother 1998, 42, 2595–2601. [Google Scholar]
- Sharma, S.K.; Dai, T.; Kharkwal, G.B.; Huang, Y.Y.; Huang, L.; Bil De Arce, V.J.; Tegos, G.P.; Hamblin, M.R. Drug discovery of antimicrobial photosensitizers using animal models. Curr. Pharm. Des 2011, 17, 1303–1319. [Google Scholar]
- Lu, L.; Rininsl, F.H.; Wittenburg, S.K.; Achyuthan, K.E.; McBranch, D.W.; Whitten, D.G. Biocidal activity of a light-absorbing fluorescent conjugated polyelectrolyte. Langmuir 2005, 21, 10154–10159. [Google Scholar]
- Chemburu, S.; Corbitt, T.S.; Ista, L.K.; Ji, E.; Fulghum, J.; Lopez, G.P.; Ogawa, K.; Schanze, K.S.; Whitten, D.G. Light-induced biocidal action of conjugated polyelectrolytes supported on colloids. Langmuir 2008, 24, 11053–11062. [Google Scholar]
- Tang, Y.L.; Zhou, Z.J.; Ogawa, K.; Lopez, G.P.; Schanze, K.S.; Whitten, D.G. Synthesis, self-assembly, and photophysical behavior of oligo phenylene ethynylenes: From molecular to supramolecular properties. Langmuir 2009, 25, 21–25. [Google Scholar]
- Tang, Y.L.; Hill, E.H.; Zhou, Z.J.; Evans, D.G.; Schanze, K.S.; Whitten, D.G. Synthesis, self-assembly, and photophysical properties of cationic oligo(p-phenyleneethynylene)s. Langmuir 2011, 27, 4945–4955. [Google Scholar]
- Zhou, Z.J.; Corbitt, T.S.; Parthasarathy, A.; Tang, Y.L.; Ista, L.F.; Schanze, K.S.; Whitten, D.G. “End-only” functionalized oligo(phenylene ethynylene)s: Synthesis, photophysical and biocidal activity. J. Phys. Chem. Lett 2010, 1, 3207–3212. [Google Scholar]
- Corbitt, T.S.; Sommer, J.R.; Chemburu, S.; Ogawa, K.; Ista, L.K.; Lopez, G.P.; Whitten, D.G.; Schanze, K.S. Conjugated polyelectrolyte capsules: Light-activated antimicrobial micro “Roach Motels”. ACS Appl. Mater. Interfaces 2009, 1, 48–52. [Google Scholar]
- Zhao, X.Y.; Pinto, M.R.; Hardison, L.M.; Mwaura, J.; Muller, J.; Jiang, H.; Witker, D.; Kleiman, V.D.; Reynolds, J.R.; Schanze, K.S. Variable band gap poly (arylene ethynylene) conjugated polyelectrolytes. Macromolecules 2006, 39, 6355–6366. [Google Scholar]
- Wang, Y.; Zhou, Z.J.; Zhu, J.S.; Tang, Y.L.; Canady, T.D.; Chi, E.Y.; Schanze, K.S.; Whitten, D.G. Dark antimicrobial mechanisms of cationic phenylene ethynylene polymers and oligomers against Escherichia coli. Polymers 2011, 3, 1199–1214. [Google Scholar]
- Lee, H.; Larson, R.G. Lipid bilayer curvature and pore formation induced by charged linear polymers and dendrimers: The effect of molecular shape. J. Phys. Chem. B 2008, 112, 12279–12285. [Google Scholar]
- Melo, M.N.; Ferre, R.; Castanho, M.A.R.B. Antimicrobial peptides: Linking partition, activity and high membrane-bound concentrations. Nat. Rev. Microbiol 2009, 7, 245–250. [Google Scholar]
- Zasloff, M. Antimicrobial peptides of multicellular organisms. Nature 2002, 415, 389–395. [Google Scholar]
- Brogden, K.A. Antimicrobial peptides: Pore formers or metabolic inhibitors in bacteria? Nat. Rev. Microbiol 2005, 3, 238–250. [Google Scholar]
- Pereira, A.H. Novel therapeutics based on cationic peptides. Curr. Pharm. Biotechnol 2006, 7, 229–234. [Google Scholar]
- Rossi, L.M.; Rangasamy, P.; Zhang, J.; Qui, X.-Q.; Wu, G.Y. Research advances in the development of peptides antibiotics. J. Pharm. Sci 2008, 97, 1060–1070. [Google Scholar]
- Devine, D.A.; Hancock, R.E.W. Cationic peptides: Distribution and mechanisms of resistance. Curr. Pharm. Des 2002, 8, 703–714. [Google Scholar]
- Song, Y.M.; Park, Y.; Lim, S.S.; Yang, S.T.; Woo, E.R.; Park, S.; Lee, J.S.; Kim, J.I.; Hahm, K.S.; Kim, Y.; et al. Cell selectivity and mechanism of action of antimicrobial model peptides containing peptoid residues. Biochemistry 2005, 44, 12094–12106. [Google Scholar]
- Fimland, G.; Johnsen, L.; Dalhus, B.; Nissen-Meyer, J. Pediocin-like antimicrobial peptides (class IIa bacteriocins) and their immunity proteins: Biosynthesis, structure, and mode of action. J. Pept. Sci 2005, 11, 688–696. [Google Scholar]
- Hancock, R.E.W.; Lehrer, R. Cationic peptides: A new source of antibiotics. Trends Biotechnol 1998, 16, 82–88. [Google Scholar]
- Toke, O. Antimicrobial peptides: New candidates in the fight against bacterial infections. Biopolymers 2005, 80, 717–735. [Google Scholar]
- Hancock, R.E.; Sahl, H.G. Antimicrobial and host-defense peptides as new anti-infective therapeutic strategies. Nat. Biotechnol 2006, 24, 1551–1557. [Google Scholar]
- McAuliffe, O.; Ross, R.P.; Hill, C. Lantibiotics: Structure, biosynthesis and mode of action. FEMS Microbiol. Rev 2001, 25, 285–308. [Google Scholar]
- Hsu, S.T.; Breukink, E.; Tischenko, E.; Lutters, M.A.; Kruijff, B.; Kaptein, R.; Bonvin, A.M.; van Nuland, N.A. The nisin-lipid II complex reveals a pyrophosphate cage that provides a blueprint for novel antibiotics. Nat. Struct. Mol. Biol 2004, 11, 963–967. [Google Scholar]
- Perlman, D.; Bodanszky, M. Biosynthesis of peptide antibiotics. Annu. Rev. Biochem 1971, 40, 449–464. [Google Scholar]
- Kleinkauf, H.; von Dohren, H. Peptide antibiotics, β-lactams and related compounds. Crit. Rev. Biotechnol 1988, 8, 1–32. [Google Scholar]
- Hancock, R.E.; Falla, T.; Brown, M.H. Cationic bactericidal peptides. Adv. Microb. Physiol 1995, 37, 135–175. [Google Scholar]
- Weidenmaier, C.; Kristian, S.A.; Peschel, A. Bacterial resistance to antimicrobial host defenses—An emerging target for novel antiinfective strategies? Curr. Drug Targets 2003, 4, 643–649. [Google Scholar]
- Koprivnjak, T.; Peschel, A. Bacterial resistance mechanisms against host defense peptides. Cell. Mol. Life Sci 2011, 68, 2243–2254. [Google Scholar]
- Saar-Dover, R.; Bitler, A.; Nezer, R.; Shmuel-Galia, L.; Firon, A.; Shimoni, E.; Trieu-Cuot, P.; Shai, Y. D-alanylation of lipoteichoic acids confers resistance to cationic peptides in group B streptococcus by increasing the cell wall density. PLoS Pathog 2012, 8, e1002891. [Google Scholar]
- Palusińska-Szysz, M.; Zdybicka-Barabas, A.; Pawlikowska-Pawlęga, B.; Mak, P.; Cytryńska, M. Anti-Legionella dumoffii activity of galleria mellonella defensin and apolipophorin III. Int. J. Mol. Sci 2012, 13, 17048–17064. [Google Scholar]
- Papagianni, M. Ribosomally synthesized peptides with antimicrobial properties: Biosynthesis, structure, function, and applications. Biotechnol. Adv 2003, 21, 465–499. [Google Scholar]
- Cotter, P.D.; Hill, C.; Ross, R.P. Bacteriocins: Developing innate immunity for food. Nat. Rev. Microbiol 2005, 3, 777–788. [Google Scholar]
- Dufour, A.; Hindré, T.; Haras, D.; Le Pennec, J.P. The biology of lantibiotics from the lacticin 481 group is coming of age. FEMS Microbiol. Rev 2007, 31, 134–167. [Google Scholar]
- Gardiner, G.E.; Rea, M.C.; O'Riordan, B.; O'Connor, P.; Morgan, S.M.; Lawlor, P.G.; Lynch, P.B.; Cronin, M.; Ross, R.P.; Hill, C. Fate of the two-component lantibiotic lacticin 3147 in the gastrointestinal tract. Appl. Environ. Microbiol 2007, 73, 7103–7109. [Google Scholar]
- Svenson, J.; Brandsdal, B.O.; Stensen, W.; Svendsen, J.S. Albumin binding of short cationic antimicrobial micropeptides and its influence on the in vitro bactericidal effect. J. Med. Chem 2007, 50, 3334–3339. [Google Scholar]
- Svenson, J.; Stensen, W.; Brandsdal, B.O.; Haug, B.E.; Monrad, J.; Svendsen, J.S. Antimicrobial peptides with stability toward tryptic degradation. Biochemistry 2008, 47, 3777–3788. [Google Scholar]
- Makovitzki, A.; Shai, Y. pH-dependent antifungal lipopeptides and their plausible mode of action. Biochemistry 2005, 44, 9775–9784. [Google Scholar]
- Chongsiriwatana, N.P.; Miller, T.M.; Wetzler, M.; Vakulenko, S.; Karlsson, A.J.; Palecek, S.P.; Mobashery, S.; Barron, A.E. Short alkylated peptoid mimics of antimicrobial lipopeptides. Antimicrob. Agents Chemother 2011, 55, 417–420. [Google Scholar]
- Chongsiriwatana, N.P.; Barron, A.E. Comparing bacterial membrane interactions of antimicrobial peptides and their mimics. Methods Mol. Biol 2010, 618, 171–182. [Google Scholar]
- Findlay, B.; Szelemej, P.; Zhanel, G.G.; Schweizer, F. Guanidylation and tail effects in cationic antimicrobial lipopeptoids. PLoS One 2012, 7, e41141. [Google Scholar]
- Findlay, B.; Zhanel, G.G.; Schweizer, F. Investigating the antimicrobial peptide “Window of activity” using cationic lipopeptides with hydrocarbon and fluorinated tails. Int. J. Antimicrob. Agents 2012, 40, 36–42. [Google Scholar]
- Munoz-Bonilla, A.; Fernandez-Garcia, M. Polymeric materials with antimicrobial activity. Prog. Polym. Sci 2012, 37, 281–339. [Google Scholar]
- Moreira Mdel, R.; Pereda, M.; Marcovich, N.E.; Roura, S.I. Antimicrobial effectiveness of bioactive packaging materials from edible chitosan and casein polymers: Assessment on carrot, cheese, and salami. J. Food Sci 2011, 76, M54–M63. [Google Scholar]
- Kuroda, K.; Caputo, G.A. Antimicrobial polymers as synthetic mimics of host-defense peptides. Wiley Interdiscip. Rev. Nanomed. Nanobiotechnol 2013, 5, 49–66. [Google Scholar]
- Timofeeva, L.; Kleshcheva, N. Antimicrobial polymers: Mechanism of action, factors of activity, and applications. Appl. Microbiol. Biotechnol 2011, 89, 475–492. [Google Scholar]
- Kenawy, E-R.; Worley, S.D.; Broughton, R. The chemistry and applications of antimicrobial polymers: A state-of-the-art review. Biomacromolecules 2007, 8, 1359–1384. [Google Scholar]
- Renani, H.B.; Ghorbani, M.; Beni, B.H.; Karimi, Z.; Mirhosseini, M.; Zarkesh, H.; Kabiri, A. Determination and comparison of specifics of nucleus pulposus cells of human intervertebral disc in alginate and chitosan-gelatin scaffolds. Adv. Biomed. Res. 2012, 1. [Google Scholar] [CrossRef]
- Totonelli, G.; Maghsoudlou, P.; Fishman, J.M.; Orlando, G.; Ansari, T.; Sibbons, P.; Birchall, M.A.; Pierro, A.; Eaton, S.; de Coppi, P. Esophageal tissue engineering: A new approach for esophageal replacement. World J. Gastroenterol 2012, 18, 6900–6907. [Google Scholar]
- Hickok, N.J.; Shapiro, I.M. Immobilized antibiotics to prevent orthopaedic implant infections. Adv. Drug Deliv. Rev 2012, 64, 1165–1176. [Google Scholar]
- Dai, T.; Tanaka, M.; Huang, Y.Y.; Hamblin, M.R. Chitosan preparations for wounds and burns: Antimicrobial and wound-healing effects. Expert Rev. Anti-Infect. Ther 2011, 9, 857–879. [Google Scholar]
- Bitar, K.N.; Raghavan, S. Intestinal tissue engineering: Current concepts and future vision of regenerative medicine in the gut. Neurogastroenterol. Motil 2012, 24, 7–19. [Google Scholar]
- Walker, P.A.; Aroom, K.R.; Jimenez, F.; Shah, S.K.; Harting, M.T.; Gill, B.S.; Cox, C.S., Jr. Advances in progenitor cell therapy using scaffolding constructs for central nervous system injury. Stem Cell Rev 2009, 5, 283–300. [Google Scholar]
- Zhang, Z.; Hu, J.; Ma, P.X. Nanofiber-based delivery of bioactive agents and stem cells to bone sites. Adv. Drug Deliv. Rev 2012, 64, 1129–1141. [Google Scholar]
- Tan, H.; Ma, R.; Lin, C.; Liu, Z.; Tang, T. Quaternized chitosan as an antimicrobial agent: Antimicrobial activity, mechanism of action and biomedical applications in orthopedics. Int. J. Mol. Sci 2013, 14, 1854–1869. [Google Scholar]
- Valencia-Chamorro, S.A.; Palou, L.; Del Río, M.A.; Pérez-Gago, M.B. Antimicrobial edible films and coatings for fresh and minimally processed fruits and vegetables: A review. Crit. Rev. Food Sci. Nutr 2011, 51, 872–900. [Google Scholar]
- Cagri, A.; Ustunol, Z.; Ryser, E.T. Antimicrobial edible films and coatings. J. Food Prot 2004, 67, 833–848. [Google Scholar]
- Vargas, M.; González-Martínez, C. Recent patents on food applications of chitosan. Recent Pat. Food Nutr. Agric 2010, 2, 121–128. [Google Scholar]
- Francolini, I.; Donelli, G. Prevention and control of biofilm-based medical-device-related infections. FEMS Immunol. Med. Microbiol 2010, 59, 227–238. [Google Scholar]
- Bridier, A.; Sanchez-Vizuete Mdel, P.; Le Coq, D.; Aymerich, S.; Meylheuc, T.; Maillard, J.Y.; Thomas, V.; Dubois-Brissonnet, F.; Briandet, R. Biofilms of a Bacillus subtilis hospital isolate protect Staphylococcus aureus from biocide action. PLoS One 2012, 7, e44506. [Google Scholar]
- Thallinger, B.; Prasetyo, E.N.; Nyanhongo, G.S.; Guebitz, G.M. Antimicrobial enzymes: An emerging strategy to fight microbes and microbial biofilms. Biotechnol. J 2013, 8, 97–109. [Google Scholar]
- Caro, A.; Humblot, V.; Méthivier, C.; Minier, M.; Salmain, M.; Pradier, C.M. Grafting of lysozyme and/or poly(ethylene glycol) to prevent biofilm growth on stainless steel surfaces. J. Phys. Chem. B 2009, 113, 2101–2109. [Google Scholar]
- Shukla, A.; Fleming, K.E.; Chuang, H.F.; Chau, T.M.; Loose, C.R.; Stephanopoulos, G.N.; Hammond, P.T. Controlling the release of peptide antimicrobial agents from surfaces. Biomaterials 2010, 31, 2348–2357. [Google Scholar]
- Melo, L.D.; Carmona-Ribeiro, A.M. Fungicidal nanoparticles of low toxicity from cationic lipid and polyelectrolytes. NSTI Nanotech 2012, 3, 350–353. [Google Scholar]
- Pereira, E.M.; Kosaka, P.M.; Rosa, H.; Vieira, D.B.; Kawano, Y.; Petri, D.F.; Carmona-Ribeiro, A.M. Hybrid materials from intermolecular associations between cationic lipid and polymers. J. Phys. Chem. B 2008, 112, 9301–9310. [Google Scholar]
- Dvoracek, C.M.; Sukhonosova, G.; Benedik, M.J.; Grunlan, J.C. Antimicrobial behavior of polyelectrolyte-surfactant thin film assemblies. Langmuir 2009, 25, 10322–10328. [Google Scholar]
- Melo, L.D.; Palombo, R.R.; Petri, D.F.S.; Bruns, M.; Pereira, E.M.A.; Carmona-Ribeiro, A.M. Structure-activity relationship for quaternary ammonium compounds hybridized with poly(methyl methacrylate). ACS Appl. Mater. Interfaces 2011, 3, 1933–1939. [Google Scholar]
- Decher, G.; Hong, J.D. Buildup of ultrathin multilayer films by a self-assembly process: II. Consecutive adsorption of anionic and cationic bipolar amphiphiles and polyelectrolytes on charged surfaces. Ber. Bunsenges. Phys. Chem 1991, 95, 1430–1434. [Google Scholar]
- Decher, G. Fuzzy nanoassemblies: Toward layered polymeric multicomposites. Science 1997, 277, 1232–1237. [Google Scholar]
- Song, J.; Kang, H.; Lee, C.; Hwang, S.H.; Jang, J. Aqueous synthesis of silver nanoparticle embedded cationic polymer nanofibers and their antibacterial activity. ACS Appl. Mater. Interfaces 2012, 4, 460–465. [Google Scholar]
- Fu, J.; Ji, J.; Yuan, W.; Shen, J. Construction of anti-adhesive and antibacterial multilayer films via layer-by-layer assembly of heparin and chitosan. Biomaterials 2005, 26, 6684–6692. [Google Scholar]
- Fu, J.; Ji, J.; Fan, D.; Shen, J. Construction of antibacterial multilayer films containing nanosilver via layer-by-layer assembly of heparin and chitosan-silver ions complex. J. Biomed. Mater. Res. A 2006, 79, 665–674. [Google Scholar]
- Cao, H.; Liu, X. Silver nanoparticles-modified films versus biomedical device-associated infections. Wiley Interdiscip. Rev. Nanomed. Nanobiotechnol 2010, 2, 670–684. [Google Scholar]
- Vieira, D.B.; Carmona-Ribeiro, A.M. Cationic nanoparticles for delivery of amphotericin B: Preparation, characterization and activity in vitro. J. Nanobiotechnol. 2008, 6. [Google Scholar] [CrossRef] [Green Version]
- Zhang, L.; Eisenberg, A. Multiple morphologies of “Crew-Cut” aggregates of polystyrene-b-poly( acrylic acid) block copolymers. Science 1995, 268, 1728–1731. [Google Scholar]
- Discher, D.E.; Eisenberg, A. Polymer vesicles. Science 2002, 297, 967–973. [Google Scholar]
- Du, J.Z.; Chen, Y.M. Organic-inorganic hybrid nanoparticles with a complex hollow structure. Angew. Chem. Int. Ed 2004, 43, 5084–5087. [Google Scholar]
- Du, J.Z.; Willcock, H.; Ieong, N.S.; O'Reilly, R.K. pH-responsive chiral nanostructures. Aust. J. Chem 2011, 64, 1041–1046. [Google Scholar]
- Du, J.Z.; Armes, S.P. Preparation of primary amine-based block copolymer vesicles by direct dissolution in water and subsequent stabilization by sol-gel chemistry. Langmuir 2008, 24, 13710–13716. [Google Scholar]
- Du, J.Z.; Armes, S.P. Preparation of biocompatible zwitterionic block copolymer vesicles by direct dissolution in water and subsequent silicification within their membranes. Langmuir 2009, 25, 9564–9570. [Google Scholar]
- Seyfriedsberger, G.; Rametsteiner, K.; Kern, W. Polyethylene compounds with antimicrobial surface properties. Eur. Polym. J 2006, 42, 3383–3389. [Google Scholar]
- Ignatova, M.; Voccia, S.; Gilbert, B.; Markova, N.; Cossement, D.; Gouttebaron, R.; Jérôme, R.; Jérôme, C. Combination of electrografting and atom-transfer radical polymerization for making the stainless steel surface antibacterial and protein antiadhesive. Langmuir 2006, 22, 255–262. [Google Scholar]
- Jiang, X.; Zhang, G.; Narain, R.; Liu, S. Fabrication of two types of shell-cross-linked micelles with “inverted” structures in aqueous solution from schizophrenic water-soluble ABC triblock copolymer via click chemistry. Langmuir 2009, 25, 2046–2054. [Google Scholar]
- Lutz, J-F. Thermo-switchable materials prepared using the OEGMA-platform. Adv. Mater 2011, 23, 2237–2243. [Google Scholar]
- Lutz, J.F.; Hoth, A. Preparation of ideal PEG analogues with a tunable thermosensitivity by controlled radical copolymerization of 2-(2-methoxyethoxy)ethyl methacrylate and oligo(ethylene glycol) methacrylate. Macromolecules 2006, 39, 893–896. [Google Scholar]
- Zhang, C.; Zhu, Y.; Zhou, C.; Yuan, W.; Du, J. Antibacterial vesicles by direct dissolution of a block copolymer in water. Polym. Chem 2013, 4, 255–259. [Google Scholar]
- Dandekar, A.M.; Gouran, H.; Ibáñez, A.M.; Uratsu, S.L.; Agüero, C.B.; McFarland, S.; Borhani, Y.; Feldstein, P.A.; Bruening, G.; Nascimento, R.; et al. An engineered innate immune defense protects grapevines from Pierce disease. Proc. Natl. Acad. Sci. USA 2012, 109, 3721–3725. [Google Scholar]
- Kiss, E.; Heine, E.T.; Hill, K.; He, Y.C.; Keusgen, N.; Pénzes, C.B.; Schnöller, D.; Gyulai, G.; Mendrek, A.; Keul, H.; et al. Membrane affinity and antibacterial properties of cationic polyelectrolytes with different hydrophobicity. Macromol. Biosci 2012, 12, 1181–1189. [Google Scholar]
- Kusumo, A.; Bombalski, L.; Lin, Q.; Matyjaszewski, K.; Schneider, J.W.; Tilton, R.D. High capacity, charge-selective protein uptake by polyelectrolyte brushes. Langmuir 2007, 23, 4448–4454. [Google Scholar]
- Lee, S.B.; Koepsel, R.R.; Morley, S.W.; Matyjaszewski, K.; Sun, Y.; Russell, A.J. Permanent, nonleaching antibacterial surfaces. 1. Synthesis by atom transfer radical polymerization. Biomacromolecules 2004, 5, 877–882. [Google Scholar]
- Roy, D.; Knapp, J.S.; Guthrie, J.T.; Perrier, S. Antibacterial cellulose fiber via RAFT surface graft polymerization. Biomacromolecules 2008, 9, 91–99. [Google Scholar]
- Huang, J.; Murata, H.; Koepsel, R.R.; Russell, A.J.; Matyjaszewski, K. Antibacterial polypropylene via surface-initiated atom transfer radical polymerization. Biomacromolecules 2007, 8, 1396–1399. [Google Scholar]
- Rawlinson, L.A.; Ryan, S.M.; Mantovani, G.; Syrett, J.A.; Haddleton, D.M.; Brayden, D.J. Antibacterial effects of poly(2-(dimethylamino ethyl)methacrylate) against selected gram-positive and gram-negative bacteria. Biomacromolecules 2010, 11, 443–453. [Google Scholar]
- Dong, H.; Huang, J.; Koepsel, R.R.; Ye, P.; Russell, A.J.; Matyjaszewski, K. Recyclable antibacterial magnetic nanoparticles grafted with quaternized poly(2-(dimethylamino)ethyl methacrylate) brushes. Biomacromolecules 2011, 12, 1305–1311. [Google Scholar]
- Wang, J.; Yao, K.; Korich, A.L.; Li, S.; Ma, S.; Ploehn, H.J.; Iovine, P.M.; Wang, C.; Chu, F.; Tang, C. Combining renewable gum rosin and lignin: Towards hydrophobic polymer composites by controlled polymerization. J. Polym. Sci. A 2011, 49, 3728–3738. [Google Scholar]
- Yancheva, E.; Paneva, D.; Maximova, V.; Mespouille, L.; Dubois, P.; Manolova, N.; Rashkov, I. Polyelectrolyte complexes between (cross-linked) N-carboxyethylchitosan and (quaternized) poly[2-(dimethylamino)ethyl methacrylate]: Preparation, characterization, and antibacterial properties. Biomacromolecules 2007, 8, 976–984. [Google Scholar]
- Chen, Y.; Wilbon, P.A.; Chen, Y.P.; Zhou, J.; Nagarkatti, M.; Wang, C.; Chu, F.; Decho, A.W.; Tang, C. Amphipathic antibacterial agents using cationic methacrylic polymers with natural rosin as pendant group. RSC Adv 2012, 2, 10275–10282. [Google Scholar]
- Bucki, R.; Sostarecz, A.G.; Byfield, F.J.; Savage, P.B.; Janmey, P.A. Resistance of the antibacterial agent ceragenin CSA-13 to inactivation by DNA of F-actin, and its activity in cystic fibrosis sputum. J. Antimicrob. Chemother 2007, 60, 535–545. [Google Scholar]
- Bucki, R.; Namiot, D.B.; Namiot, Z.; Savage, P.B.; Janmey, P.A. Salivary mucins inhibit antibacterial activity of cathelicidin-derived LL-37 peptide but not the cationic steroid CSA-13. J. Antimicrob. Chemother 2008, 62, 329–335. [Google Scholar]
- Epand, R.F.; Pollard, J.E.; Wright, J.O.; Savage, P.B.; Epand, R.M. Depolarization, bacterial membrane composition, and the antimicrobial action of ceragenins. Antimicrob. Agents Chemother 2010, 54, 3708–3713. [Google Scholar]
- Lewis, K. Persister cells, dormancy and infectious disease. Nat. Rev. Microbiol 2007, 5, 48–56. [Google Scholar]
- Coates, A.R.; Hu, Y. Targeting non-multiplying organisms as a way to develop novel antimicrobials. Trends Pharmacol. Sci 2008, 29, 143–150. [Google Scholar]
- Hurdle, J.G.; O'Neill, A.J.; Chopra, I.; Lee, R.E. Targeting bacterial membrane function: An underexploited mechanism for treating persistent infections. Nat. Rev. Microbiol 2011, 9, 62–75. [Google Scholar]
- Barry, C.E.; Boshoff, H.I.; Dartois, V.; Dick, T.; Ehrt, S.; Flynn, J.; Schnappinger, D.; Wilkinson, R.J.; Young, D. The spectrum of latent tuberculosis: Rethinking the biology and intervention strategies. Nat. Rev. Microbiol 2009, 7, 845–855. [Google Scholar]
- Sinclair, K.D.; Pham, T.X.; Farnsworth, R.W.; Williams, D.L.; Loc-Carrillo, C.; Horne, L.A.; Ingebretsen, S.H.; Bloebaum, R.D. Development of a broad spectrum polymer-released antimicrobial coating for the prevention of resistant strain bacterial infections. J. Biomed. Mater. Res. A 2012, 100A, 2732–2738. [Google Scholar]
- Green, J.B.; Fulghum, T.; Nordhaus, M.A. Review of immobilized antimicrobial agents and methods for testing. Biointerphases 2011, 6, CL2–CL43. [Google Scholar]
- Engler, A.C.; Shukla, A.; Puranam, S.; Buss, H.G.; Jreige, N.; Hammond, P.T. Effects of side group functionality and molecular weight on the activity of synthetic antimicrobial polypeptides. Biomacromolecules 2011, 12, 1666–1674. [Google Scholar]
- Radzishevsky, I.S.; Rotem, S.; Bourdetsky, D.; Navon-Venezia, S.; Carmeli, Y.; Mor, A. Improved antimicrobial peptides based on acyl-lysine oligomers. Nat. Biotechnol 2007, 25, 657–659. [Google Scholar]
- Tew, G.N.; Scott, R.W.; Klein, M.L.; Degrado, W.F. De novo design of antimicrobial polymers, foldamers, and small molecules: from discovery to practical applications. Acc. Chem. Res 2010, 43, 30–39. [Google Scholar]
- Sovadinova, I.; Palermo, E.F.; Huang, R.; Thoma, L.M.; Kuroda, K. Mechanism of polymer-induced hemolysis: Nanosized pore formation and osmotic lysis. Biomacromolecules 2011, 12, 260–268. [Google Scholar]
- Stratton, T.R.; Applegate, B.M.; Youngblood, J.P. Effect of steric hindrance on the properties of antibacterial and biocompatible copolymers. Biomacromolecules 2011, 12, 50–56. [Google Scholar]
- Lienkamp, K.; Madkour, A.E.; Musante, A.; Nelson, C.F.; Nüsslein, K.; Tew, G.N. Antimicrobial polymers prepared by ROMP with unprecedented selectivity: A molecular construction kit approach. J. Am. Chem. Soc 2008, 130, 9836–9843. [Google Scholar]
- Li, P.; Poon, Y.F.; Li, W.; Zhu, H.Y.; Yeap, S.H.; Cao, Y.; Qi, X.; Zhou, C.; Lamrani, M.; Beuerman, R.W.; et al. A polycationic antimicrobial and biocompatible hydrogel with microbe membrane suctioning ability. Nat. Mater 2011, 10, 149–156. [Google Scholar]
- Li, P.; Zhou, C.; Rayatpisheh, S.; Ye, K.; Poon, Y.F.; Hammond, P.T.; Duan, H.; Chan-Park, M.B. Cationic peptidopolysaccharides show excellent broad-spectrum antimicrobial activities and high selectivity. Adv. Mater 2012, 24, 4130–4137. [Google Scholar]
- Wang, R.; Wang, L.; Zhou, L.; Su, Y.; Qiu, F.; Wang, D.; Wu, J.; Zhu, X.; Yan, D. The effect of a branched architecture on the antimicrobial activity of poly(sulfone amines) and poly(sulfone amine)/silver nanocomposites. J. Mater. Chem 2012, 22, 15227–15234. [Google Scholar]
- Fox, M.E.; Szoka, F.C.; Fréchet, J.M. Soluble polymer carriers for the treatment of cancer: The importance of molecular architecture. Acc. Chem. Res 2009, 42, 1141–1151. [Google Scholar]
- Oikonomou, E.K.; Bethani, A.; Bokias, G.; Kallitsis, J.K. Poly (sodium styrene sulfonate)-b-poly( methyl methacrylate) diblock copolymers through direct atom transfer radical polymerization: Influence of hydrophilic-hydrophobic balance on self-organization in aqueous solution. Eur. Polym. J 2011, 47, 752–761. [Google Scholar]
- Song, J.; Kong, H.; Jang, J. Enhanced antibacterial performance of cationic polymer modified silica nanoparticles. Chem. Commun. (Camb.) 2009, 36, 5418–5420. [Google Scholar]
- Nigmatullin, R.; Gao, F.; Konovalova, V. Permanent, non-leaching antimicrobial polyamide nanocomposites based on organoclays modified with a cationic polymer. Macromol. Mater. Eng 2009, 294, 795–805. [Google Scholar]
- Qian, L.; Guan, Y.; Ziaee, Z.; He, B.; Zheng, A.; Xiao, H. Rendering cellulose fibers antimicrobial using cationic β-cyclodextrin-based polymers included with antibiotics. Cellulose 2009, 16, 309–317. [Google Scholar]
- Pan, Y.; Xiao, H.; Zhao, G.; He, B. Antimicrobial and thermal-responsive layer-by-layer assembly based on ionic-modified guanidine polymer and PVA. Polym. Bull 2008, 61, 541–551. [Google Scholar]
- Pfaffenroth, C.; Winkel, A.; Dempwolf, W.; Gamble, L.J.; Castner, D.G.; Stiesch, M.; Menzel, H. Self-assembled antimicrobial and biocompatible copolymer films on titanium. Macromol. Biosci 2011, 11, 1515–1525. [Google Scholar]
- Malmsten, M. Antimicrobial and antiviral hydrogels. Soft Matter 2011, 7, 8725–8736. [Google Scholar]
- Llorens, A.; Lloret, E.; Picouet, P.A.; Trbojevich, R.; Fernandez, A. Metallic-based micro and nanocomposites in food contact materials and active food packaging. Trends Food Sci. Technol 2012, 24, 19–29. [Google Scholar]
- Seil, J.T.; Webster, T.J. Antimicrobial applications of nanotechnology: Methods and literature. Int. J. Nanomedicine 2012, 7, 2767–2781. [Google Scholar]
- Li, Y.; Hindi, K.; Watts, K.M.; Taylor, J.B.; Zhang, K.; Li, Z.; Hunstad, D.A.; Cannon, C.L.; Youngs, W.J.; Wooley, K.L. Shell crosslinked nanoparticles carrying silver antimicrobials as therapeutics. Chem. Commun. (Camb.) 2010, 46, 121–123. [Google Scholar]
- Ran, J.; Bénistant, G.; Campagne, C.; Périchaud, A.; Chai, F.; Blanchemain, N.; Perwuelz, A. Characterization of nonwoven poly(ethylene terephtalate) devices functionalized with cationic polymer. J. Appl. Polym. Sci 2012, 124, 3583–3590. [Google Scholar]
- Pan, Y.; Xiao, H. Rendering rayon fibres antimicrobial and thermal-responsive via layer-by-layer self-assembly of functional polymers. Adv. Mater. Res. 2011, 1103–1106. [Google Scholar]
- Kemp, M.M.; Kumar, A.; Clement, D.; Ajayan, P.; Mousa, S.; Linhardt, R.J. Hyaluronan- and heparin-reduced silver nanoparticles with antimicrobial properties. Nanomedicine (Lond.) 2009, 4, 421–429. [Google Scholar]
- Chen, J.; Hessler, J.A.; Putchakayala, K.; Panama, B.K.; Khan, D.P.; Hong, S.; Mullen, D.G.; Dimaggio, S.C.; Som, A.; Tew, G.N.; et al. Cationic nanoparticles induce nanoscale disruption in living cell plasma membranes. J. Phys. Chem. B 2009, 113, 11179–11185. [Google Scholar]
- Leroueil, P.R.; Berry, S.A.; Duthie, K.; Han, G.; Rotello, V.M.; McNerny, D.Q.; Baker, J.R., Jr; Orr, B.G.; Holl, M.M. Wide varieties of cationic nanoparticles induce defects in supported lipid bilayers. Nano Lett 2008, 8, 420–424. [Google Scholar]
- Epand, R.F.; Mowery, B.P.; Lee, S.E.; Stahl, S.S.; Lehrer, R.I.; Gellman, S.H.; Epand, R.M. Dual mechanism of bacterial lethality for a cationic sequence-random copolymer that mimics host-defense antimicrobial peptides. J. Mol. Biol 2008, 379, 38–50. [Google Scholar]
- Fröhlich, E. The role of surface charge in cellular uptake and cytotoxicity of medical nanoparticles. Int. J. Nanomed 2012, 7, 5577–5591. [Google Scholar]
- Rawlinson, L.A.; O'Gara, J.P.; Jones, D.S.; Brayden, D.J. Resistance of Staphylococcus aureus to the cationic antimicrobial agent poly(2-(dimethylamino ethyl)methacrylate) (pDMAEMA) is influenced by cell-surface charge and hydrophobicity. J. Med. Microbiol 2011, 60, 968–976. [Google Scholar]
- Rawlinson, L.A.; O'Brien, P.J.; Brayden, D.J. High content analysis of cytotoxic effects of pDMAEMA on human intestinal epithelial and monocyte cultures. J. Control. Release 2010, 146, 84–92. [Google Scholar]
- Nederberg, F.; Zhang, Y.; Tan, J.P.; Xu, K.; Wang, H.; Yang, C.; Gao, S.; Guo, X.D.; Fukushima, K.; Li, L.; et al. Biodegradable nanostructures with selective lysis of microbial membranes. Nat. Chem 2011, 3, 409–414. [Google Scholar]
- Nitta, S.K.; Numata, K. Biopolymer-based nanoparticles for drug/gene delivery and tissue engineering. Int. J. Mol. Sci 2013, 14, 1629–1654. [Google Scholar]
- Kayitmazer, A.B.; Strand, S.P.; Tribet, C.; Jaeger, W.; Dubin, P.L. Effect of polyelectrolyte structure on protein-polyelectrolyte coacervates: Coacervates of bovine serum albumin with poly (diallyldimethylammonium chloride) versus chitosan. Biomacromolecules 2007, 8, 3568–3577. [Google Scholar]
- Chang, Y.; McLandsborough, L.; McClements, D.J. Cationic antimicrobial (ɛ-polylysine)-anionic polysaccharide (pectin) interactions: Influence of polymer charge on physical stability and antimicrobial efficacy. J. Agric. Food Chem 2012, 60, 1837–1844. [Google Scholar]
- Jones, O.G.; McClements, D.J. Recent progress in biopolymer nanoparticle and microparticle formation by heat-treating electrostatic protein-polysaccharide complexes. Adv. Colloid Interface Sci 2011, 167, 49–62. [Google Scholar]
- Wandrey, C.; Hernandez-Barajas, J.; Hunkeler, D. Diallyldimethylammonium chloride and its polymers. Adv. Polym. Sci 1999, 145, 123–183. [Google Scholar]
- Som, A.; Tew, G.N. Influence of lipid composition on membrane activity of antimicrobial phenylene ethynylene oligomers. J. Phys. Chem. B 2008, 112, 3495–3502. [Google Scholar]

| Cationic molecule or assembly | Name | References |
|---|---|---|
![]() | Dioctadecyldimethylammonium bromide (DODAB) | [16,17,23–27] |
![]() | Cationic bilayer fragment (A) Large cationic vesicle (B) | [36–42] |
![]() | Hexadecyltrimethylammonium bromide (CTAB) | [43,44] |
![]() | CTAB micelle | [43,44] |
![]() | Poly (diallyldimethyl) ammonium chloride (PDDA) | [45] |
![]() | Cationic bilayer fragment/carboxymethylcellulose (CMC)/PDDA nanoparticle | [45] |
![]() | Polystyrene sulfate nanoparticle supporting a DODAB cationic bilayer | [46,47] |
| Cell type | Cells/mL | [DODAB], mM (μg/mL) | References | |
|---|---|---|---|---|
| 50% survival | 0% survival | |||
| Mammalian cells | ||||
| Kidney epithelial cells | 105 | 5.4 (3,400) | - | [27] |
| 3T3(cloneA31) fibroblasts | 104 | 1.0 (631) | - | [109,110] |
| SV40-SVT2 fibroblasts | 104 | 1.0 (631) | - | [109,110] |
| Gram-negative bacteria | ||||
| E. coli | 2 × 107 | 0.028 (17.7) | - | [16,17,23,24,109] |
| S. typhimurium | 2 × 107 | 0.010 (6.3) | - | [16,17,109] |
| P. aeruginosa | 3 × 107 | 0.005 (3.2) | - | [16,17,109] |
| Gram-positive bacteria | ||||
| S. aureus | 3 × 107 | 0.006 (3.8) | - | [16,17,109] |
| Yeasts | ||||
| C. albicans ATCC 90028 * | 103 | - | 0.4 (250) | [27] |
| C. albicans ATCC 90028 | 2 × 106 | 0.010 (6.3) | - | [25,109] |
| Synthetic peptide ref. [138] | Antimicrobial polymer ref. [45] |
![]() | ![]() |
| Synthetic peptoid ref. [139] | Antimicrobial copolymer ref. [140] |
![]() | ![]() |
| Peptide-mimetic antimicrobial polymers ref. [91,141,142] | |
![]() | |
| Dispersion | MBC or MFC (μg/mL) | % Haemolysis ref. [213] | |||||
|---|---|---|---|---|---|---|---|
| [PDDA] | [DODAB] | [PDDA] | [DODAB] | [PDDA] | [DODAB] | ||
| P. aeruginosa ref. [45] | S. aureus ref. [45] | C. albicans ref. [213] | |||||
| SP | 2.0 | 1.0 | 10.0 | 6.0 | 0.5 | 0.32 | 0 |
| LP | 2.0 | 1.0 | 10.0 | 6.0 | 1.0 | 0.63 | 0 |
| Polymer | Microrganism | MIC (μg/mL) | Haemolysis | Ref. |
|---|---|---|---|---|
| Polyionene 5 | P. aeruginosa | 100–330 | Nt | [86] |
| S. aureus | 5–10 | |||
| Polyionene 14 | P. aeruginosa | 330–660 | Nt | [86] |
| S. aureus | 33–66 | |||
| Lipopeptoid | P. aeruginosa | 64 | 56% (at 100 μg/mL lipopeptoid) | [190] |
| C16NlysGNlys | S. aureus | 8 | ||
| Lipopeptoid | P. aeruginosa | 128 | 68% (at 100 μg/mL lipopeptoid) | [190] |
| C16NlysNlysNlys | S. aureus | 16 | ||
| Lipopeptide | P. aeruginosa | * 128 | 4% (at 100 μg/mL lipopeptide) | [191] |
| C16-KKK | S. aureus | * 16 | ||
| Lipopeptide | P. aeruginosa | * 64 | 63% (at 100 μg/mL lipopeptide) | [191] |
| C16-KGK | S. aureus | * 8 | ||
| pDMAEMA | P. aeruginosa | 1000 | 50% | [242] |
| S. epidermidis | 100 | >10 mg/mL | ||
| PDDA | P. aeruginosa | ** 1.0 | 0% (at 100 μg/mL) | [45,213] |
| S. aureus | ** 10 | |||
| C. albicans | ** 0.5 | |||
© 2013 by the authors; licensee MDPI, Basel, Switzerland This article is an open access article distributed under the terms and conditions of the Creative Commons Attribution license (http://creativecommons.org/licenses/by/3.0/).
Share and Cite
Carmona-Ribeiro, A.M.; De Melo Carrasco, L.D. Cationic Antimicrobial Polymers and Their Assemblies. Int. J. Mol. Sci. 2013, 14, 9906-9946. https://doi.org/10.3390/ijms14059906
Carmona-Ribeiro AM, De Melo Carrasco LD. Cationic Antimicrobial Polymers and Their Assemblies. International Journal of Molecular Sciences. 2013; 14(5):9906-9946. https://doi.org/10.3390/ijms14059906
Chicago/Turabian StyleCarmona-Ribeiro, Ana Maria, and Letícia Dias De Melo Carrasco. 2013. "Cationic Antimicrobial Polymers and Their Assemblies" International Journal of Molecular Sciences 14, no. 5: 9906-9946. https://doi.org/10.3390/ijms14059906
APA StyleCarmona-Ribeiro, A. M., & De Melo Carrasco, L. D. (2013). Cationic Antimicrobial Polymers and Their Assemblies. International Journal of Molecular Sciences, 14(5), 9906-9946. https://doi.org/10.3390/ijms14059906













